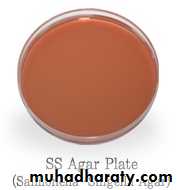
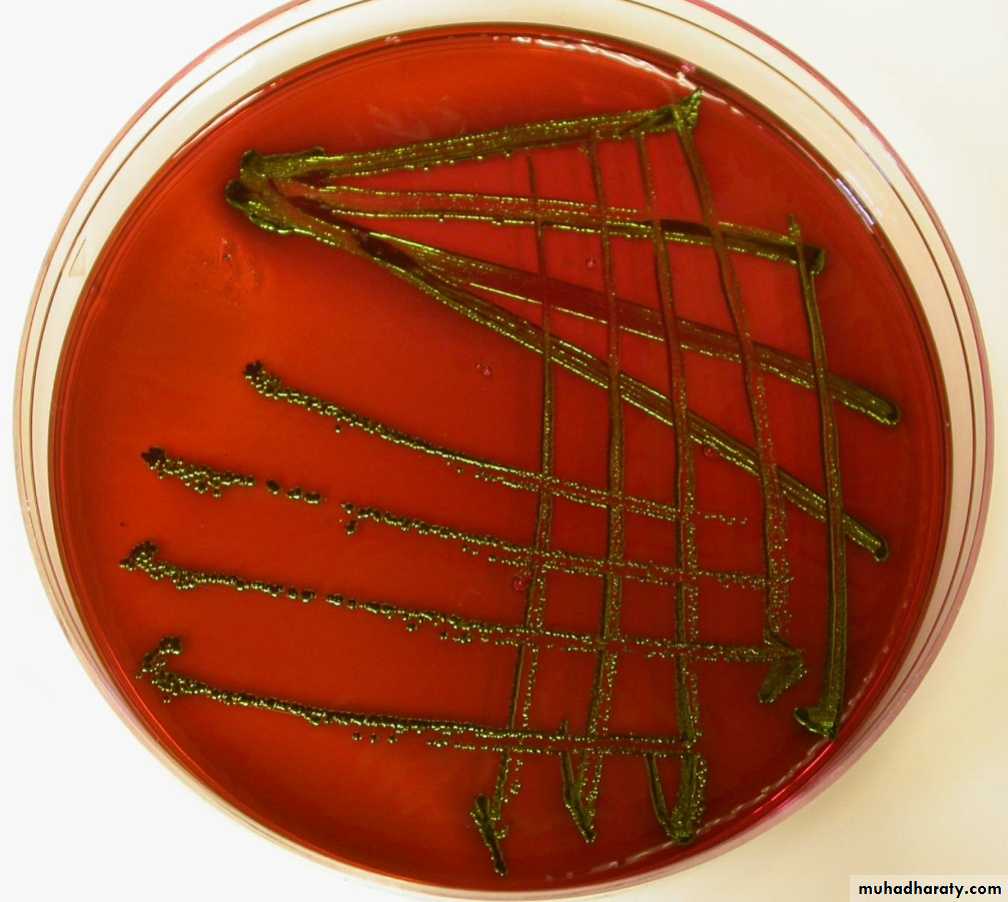
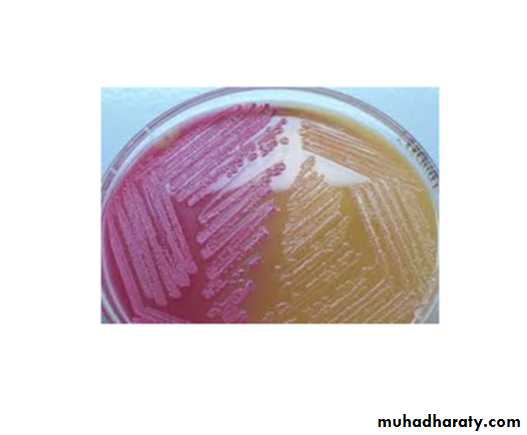
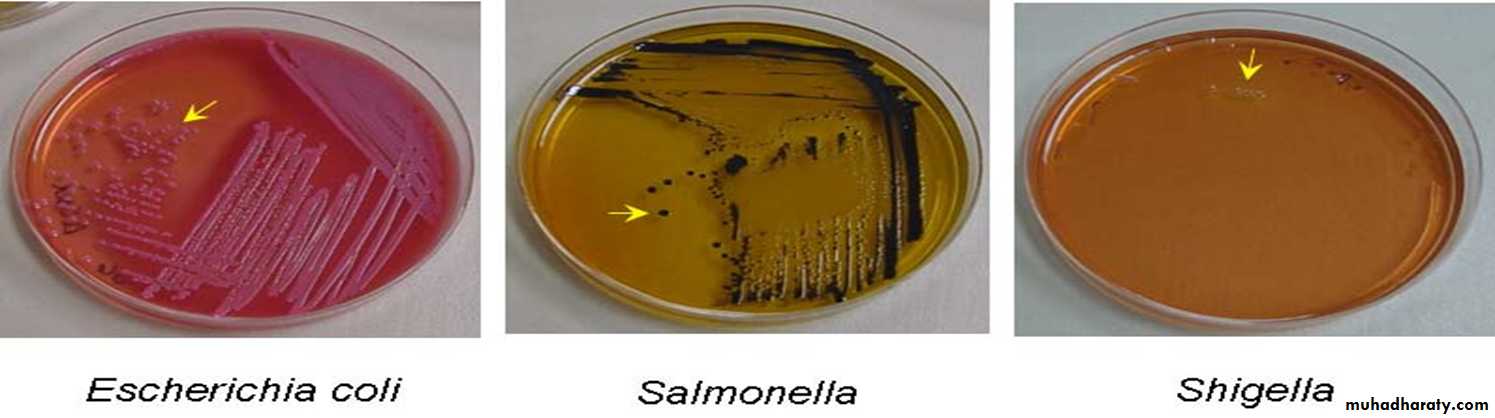
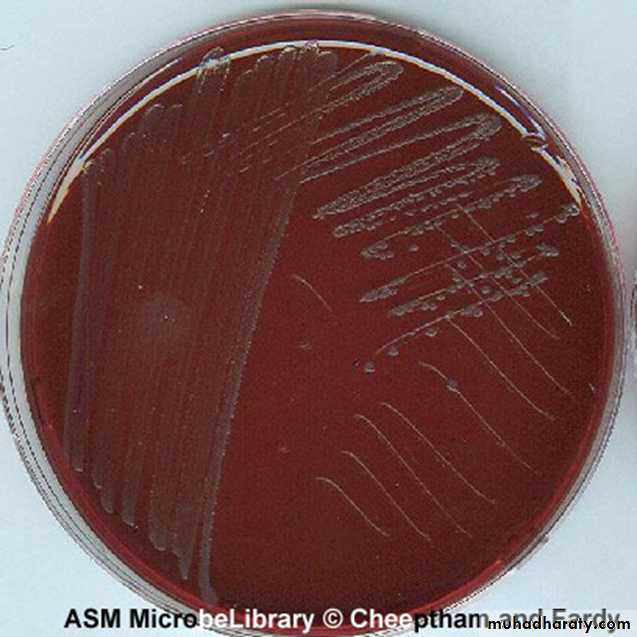

Enterobacteriaceae
Practical Microbiologyد.وليد خالد سعدون
جراثيم / د.وليد / طب عام ثالث
عملي 28/2/2017
59
ENTEROBACTERIACEAE are a big family of Gram negative bacilli containing 31 genera and 139 species. Some are regular pathogens and others are normal flora .
-They are divided into TWO main groups according to their ability to ferment LACTOSE :
-Lactose Fermenters (LF)
E. coli, Klbesiella, Citrobacter, Enterobacter-Non-Lactose Fermenters (NLF)
Salmonella, Shigella, Proteus, YersiniaGeneral Characters of Enterobacteriaceae
• All Enterobacteriaceae are:• Gram-negative bacilli
• Facultative anaerobic
• Motile except Shigella and Klebsiella
• Non-capsulated except Klebsiella
• Grow on bile salts containing media (MacConkey agar)
• Ferment glucose with acid production
• Oxidase negative
• Catalase positive
• Reduce nitrate to nitrite
METHODS OF IDENTIFICATION OF enterobacteriaceae
1-GRAM STAIN2-CULTURE MEDIA
• A-MacConkey agar
• B-Salmonella Shigella (SS) agar
• C-Eosin Methylene Blue (EMB) agar
• D-Triple Sugar Iron (TSI) agar
3-BIOCHEMICAL REACTIONS
A- IMViC REACTIONS
B- UREASE TEST
4-MOTILITY TEST
1-GRAM STAIN
-All Enterobacteriaceae are Gram-negative bacilli. They are all motile except Shigella and Klebsiella, and they are all non-capsulated except Klebsiella.2-CULTURE MEDIA
There are several selective and differential media used to isolate and distinguish between members of family enterobacteriaceae.
The most important media are:
• A-MacConkey agar• B-Salmonella Shigella (SS) agar
• C-Eosin Methylene Blue (EMB) agar
• D-Triple Sugar Iron (TSI) agar
A-MacConkey agar
- MacConkey (Mac) agar is a selective and differential medium used for the isolation of Enterobacteriaceae from stool , urine and other specimens.-Lactose fermenters will produce bright pink colonies.
While non-lactose fermenters will produce transparent (colorless) colonies.B-Salmonella Shigella (SS) agar
• SS agar is a selective & differential medium used for the isolation of Salmonella and Shigella• The appearance of Enterobacteriaceae on SS agar will be as follow:
- Non lactose fermenters, such as Shigella, produce colorless colonies.- Lactose fermenters, such as E. coli, produce pink colonies.
• - Salmonella produce colorless colonies with black centers due to H2S production.
• C-Eosin Methylene Blue (EMB) agar
-It is selective and differential medium used for the isolation and differentiation of Enterobacteriaceae.-Lactose fermenters produce blue-black colonies while Salmonella and Shigella colonies are colorless.
-E.coli colonies may show a characteristic green metallic sheen due to rapid fermentation of lactose.
Green metallic sheen produced by E.coli colonies on Eosin Methylene Blue (EMB) agar
Summary of morphology, cultural characteristics,and biochemical reactions of Enterobacteriaceae
• EMB
• SS
• MacConkey
• Nitrate reductase
• Oxidase
• Gram stain
• Metallic sheen
• LF
• LF
• +ve
• -ve
• -ve rod
• E. coli
• Dark
• LF
• LF
• +ve
• -ve
• -ve rods
• Citrobacter
• Dark
• LF
• LF
• +ve
• -ve
• -ve rods
• Klebsiella
• Dark
• LF
• LF
• +ve
• -ve
• -ve rods
• Enterobacter
• Colorless
• NLF/H2S
• NLF
• +ve
• -ve
• -ve rods
• Salmonella
• Colorless
• NLF
• NLF
• +ve
• -ve
• -ve rods
• Shigella
• Colorless
• NLF/H2S
• NLF
• +ve
• -ve
• -ve rods
• Proteus
D-Triple Sugar Iron (TSI) agar
• It differntiates enterobacteriaceae according to:
• 1-Lactose fermentation.
• 2-H2S production.
• 3-Gas production.
• - TSI agar has slant and butt
Triple Sugar Iron (TSI) agar
SlantButt
-Lactose fermenters cause yellowish discoloration of both the butt and slant like E.coli and Klebsiella.
-While in non-lactose fermenters only the butt will be yellow while the slant is red like Shigella.
Lactose fermenters
Non-lactose fermenters
-If the bacteria produce H2S (like Salmonella) it will cause black discoloration in the TSI agar, and if it is gas producer it will produce bubbles or crack in the medium.
- So the TSI agar reaction will be read as follow:
Reaction in the slant (K or A) / Reaction in the butt (K or A) + H2S ( if present ) + Gas ( if present )
E.coli= A/A
Salmonella = K/A+H2S
(A)- IMViC REACTIONS(B)- Urease Test
• IMViC reactions are set of four useful reactions that distinguish between members of the Enterobacteriaceae family based on their metabolic by-products.• The four reactions are: Indole test, Methyl Red test, Voges Proskauer test and Citrate utilization test. The letter “i” is only used for spelling purpose.
3-BIOCHEMICAL REACTIONS
INDOLE TEST
Principle of Indole test is to detect bacteria that can produce indole from amino acid tryptophan using the enzyme typtophanase.Tryptophane Tryptophanase Indole + Pyurvic acid + NH3
(amino acids)-Production of indole is indicated by the addition of Kovac’s reagent (which contains para-dimethyl aminobenzaldehyde, alcohol and concentrated HCl)
-Indole reacts with the aminobenzaldehyde in the Kovac’s reagent giving a red color at the top of the reaction.
Procedure:-
-Inoculate the medium and incubate for 48 hours at 37 C . Add 5 ml of Kovac’s Reagent and shake gently , formation of red ring indicate a positive reactionMedium:-
Peptone water ( with double concentration of peptone ).
• Tryptophane Tryptophanase Indole + Pyurvic acid + NH3
(amino acids) Kovac’s Reagent
Red color ring in the top
(1)
(2)(3)
Example:-
Escherichia coli: Positive;
Klebsiella pneumoniae: Negative
METHYL RED (MR) TEST
Principle:-It is used to detect the ability of an organism to produce large amounts of acid (pH ≤ 4.4) from glucose fermentation. Methyl red is a pH indicator, which becomes red in color at a pH of 4.4 or less.Medium :-
Glucose phosphate peptone water• Procedure:-
• The bacterium to be tested is inoculated into glucose phosphate peptone water which contains glucose and a phosphate buffer and incubated at 35C for 4 days.•
-The pH of the medium is then tested by the addition of 5 drops of MR reagent.
-Development of red color is taken as positive. While yellow color indicates MR negative organism.
Example:-
• Eschericihia coli: Positive;
• Klebsiella pneumoniae: Negative
Positive red color (e.g E.coli)
Negative yellow color (e.g klebsella)Methyl Red (MR) test
VOGES PROSKAUER (VP) TEST
Principle:-It is used to detect bacteria that produce Acetyl-methyl carbinol (acetoin) during glucose fermentation.
If acetoin is present, it is oxidized in the presence of air and KOH to diacetyl acetoin.
Acetoin + 40%KOH Diacetyl acetoin
• Diacetyl acetoin then reacts with guanidine components of peptone in which bacteria is inoculated in the presence of alphanaphthol to produce red color.
alphanaphthol
Diacetyl + Guanidine Red color
acetoin
Medium :-
Glucose phosphate peptone water
Procedure:-
-Inoculate the bacteria into glucose phosphate broth and incubate for at least 48 hours.-0.2 ml of 40% KOH is added to the broth and shaken.
-Then 0.6 ml of alpha-naphthol is added to the test broth and it is shaken.
-The tube is allowed to stand for 15 minutes.
Appearance of red color is considered as a positive test.
Examples: Escherichia coli: Negative
Klebsiella pneumoniae: Positive
Vogus proskour (VP)
CITRATE UTILIZATION TEST
Principle: This test detects the ability of an organism to utilize citrate as the sole source of carbon and ammonium salts as the sole source of nitrogen .Medium :-
Simmone’s Citrate media
• Procedure:-
• Bacteria to be tested is inoculated on a medium (Simmone’s Citrate media) containing sodium citrate, ammonium salt and a pH indicator bromothymol blue (it is green in color normally but become blue in alkaline pH).Simmone’s Citrate media
sodium citrate +ammonium saltssodium carbonate + ammonium hydroxide
Alkaline,↑pH
Bromothymol blueBlue colour
Positive test
UtilizationUtilization of sodium citrate and ammonium salts in the medium by the bacteria will produce sodium carbonate and ammonium hydroxide respectively . Both of them are alkaline compounds that will raise the pH in the media changing the color of bromothymol blue from green to blue .
Examples: Escherichia coli: Negative;
Klebsiella pneumoniae: Positive• Citrate utilization
• VP• MR
• Indole
• Bacterium
• -
• -
• +
• +
• E. coli
• +
• +
• -
• -
• K.pneumoniae
(B)- Urease Test
Principle:
-To detect organisms that produce urease which is an enzyme that catalyzes the conversion of urea to CO2 and NH3.
Urea
CO2 + NH3↑ in pH
Phenol RedPink
Positive test
Urease
• -Positive test is indicated by changing the color of the medium from yellow to pink.
• -Proteus give positive reaction after 4 hr.s while Kelebsiella and Enterobacter give positive results after 24 hr.s•
Positive test ( pink )
Negative test ( yellow )4-MOTILITY TEST
Semisolid medium
• -This test is based on the presence of the bacterial flagella.• If the bacteria have flagella, the semisolid medium will be cloudy and the test will be positive.
• -All enterobacteriaceae are motile except Shigella and Kliebsella
1-GRAM STAIN
2-CULTURE MEDIA• A-MacConkey agar
• B-Salmonella Shigella (SS) agar
IDENTIFICATION of enterobacteriaceae
• C-Eosin Methylene Blue (EMB) agar
• D-Triple Sugar Iron (TSI) agar
3-BIOCHEMICAL REACTIONS
A- IMViC REACTIONSB- UREASE TEST
4-MOTILITY TESTSummary of morphology, cultural characteristics,
and biochemical reactions of Enterobacteriaceae• EMB
• SS
• MacConkey
• Nitrate reductase
• Oxidase
• Gram stain
• Metallic sheen
• LF
• LF
• +ve
• -ve
• -ve rod
• E. coli
• Dark
• LF
• LF
• +ve
• -ve
• -ve rods
• Citrobacter
• Dark
• LF
• LF
• +ve
• -ve
• -ve rods
• Klebsiella
• Dark
• LF
• LF
• +ve
• -ve
• -ve rods
• Enterobacter
• Colorless
• NLF/H2S
• NLF
• +ve
• -ve
• -ve rods
• Salmonella
• Colorless
• NLF
• NLF
• +ve
• -ve
• -ve rods
• Shigella
• Colorless
• NLF/H2S
• NLF
• +ve
• -ve
• -ve rods
• Proteus